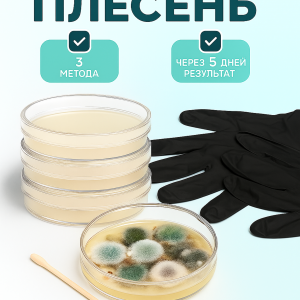

Готовый субстрат для выращивания грибов – универсальное решение для домашних и профессиональных грибоводов!
Наш субстрат подходит для таких культур, как тополиный опёнок, ежовик гребенчатый, ганодерма многоплодная, вёшенки, шиитаке и другие виды, требующие питательной, сбалансированной среды. Состав включает чистые древесные опилки без клея и вредных примесей, пшеничные отруби и гипс в оптимальных пропорциях, рассчитанных на один субстрат.
Преимущества:
- Полностью готовый к использованию – не нужно подбирать компоненты самостоятельно.
- Высокое качество сырья – отсутствие токсичных добавок.
- Прочный пакет (80 мкм) для выращивания в комплекте – гарантии гигиены и удобства.
- Экологичность и безопасность – залог здорового роста грибов и отличного вкуса.
Примечание: Данный субстрат не является стерильным. Перед использованием его необходимо стерилизовать. К товару прилагается подробная инструкция по проведению стерилизации, чтобы вы могли без труда подготовить субстрат к выращиванию и получить максимальный урожай.

Отзывы
Отзывов пока нет.